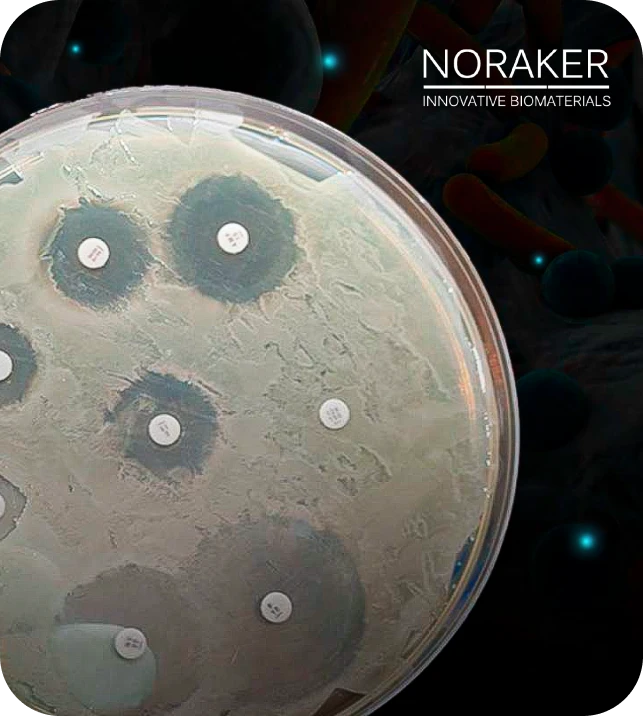

AktiBONE
Vidro bioativo 45S5
Um dispositivo sintético, bioativo e reabsorvível destinado ao preenchimento de defeitos ósseos em adultos e crianças.



Benefícios:
BIOATIVIDADE:
Formação de uma camada mineral biológica ativa, responsável por adesão direta do biomaterial e do osso.
ESTÍMULO ÓSSEO:
O aumento na concentração de íons de silício estimula geneticamente a diferenciação e a proliferação de osteoblastos, que estão envolvidos na regeneração óssea.
PROPRIEDADES HIFROFÍLICAS E ADERÊNCIA:
Afinidade com fluídos biológicos, favorável para o manuseio
SINTÉTICO:
Composto por elementos minerais.
Assista o vídeo da tecnologia:
Princípio ativo:
Uma ativação genética, para melhor remodelagem óssea.
Formação de uma camada mineral biológica ativa, responsável por adesão direta do biomaterial e do osso.
Depois da implantação, o aglutinante é rapidamente absorvido para permitir a colonização celular e vascular dos grânulos.
Os grânulos bioativos (granulometria 0,09 a 0,71 mm) são compostos unicamente por elementos presentes naturalmente no tecido ósseo (Ca, P, Na, Si, O).
A liberação desses íons durante a reabsorção dos grânulos de vidro bioativo permitirá a formação à superfície de uma camada de hidroxiapatita carbonatada, cuja composição e estrutura são similares à fase mineral do osso.

Indicações:
- Osteomielite
- Infecções ósseas
- Preenchimento de cavidades císticas
- Cirurgias da coluna e Neuro
- Buco Maxilo Facial
- Preenchimento das cavidades ósseas
- Quadril
- Tornozelo
- Preenchimento de cavidades tumorais
- Fraturas
- Revisão de Prótese
- Cistos ósseos
Inibição Bacteriana
Um inibidor do crescimento bacteriano, fato este que o torna altamente diferenciado.
- A sílica (SiO2) é altamente osmótica, absorvendo água dos tecidos locais, formando um gel;
- Este processo aumenta o PH local, impedindo a proliferação bacteriana (bacteriostático);
- Durante o processo de absorção da água, ocorre liberação dos íons de calcio e fosfatos do enxerto ósseo;
- Pelo excesso de elétrons disponíveis na superfície, ocorre a deposição do cálcio e fósforo sobre o gel, ainda nas primeiras horas, formando uma membrana.
Para saber mais sobre o Noraker Aktibone ou receber contato de um expert do nosso time para uma solução personalizada, clique no botão ao lado:abaixo:


